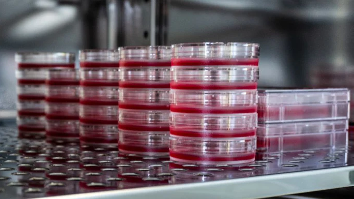
Cell Lines

Loading RSS feed...
A1
A2
A3
A4
A5
A6
A7
A8
A9
A10
B1
B2
B3
B4
B5
B6
B7
B8
B9
B10
C1
C2
C3
C4
C5
C6
C7
C8
C9
C10
D1
D2
D3
D4
D5
D6
D7
D8
D9
D10
E1
E2
E3
E4
E5
E6
E7
E8
E9
E10
F1
F2
F3
F4
F5
F6
F7
F8
F9
F10
G1
G2
G3
G4
G5
G6
G7
G8
G9
G10
H1
H2
H3
H4
H5
H6
H7
H8
H9
H10
I1
I2
I3
I4
I5
I6
I7
I8
I9
I10
J1
J2
J3
J4
J5
J6
J7
J8
J9
J10